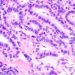

1. Double-lung transplant is associated with lower 5-year mortality rates than single-lung transplant in patients with idiopathic pulmonary fibrosis (IPF).
2. There is no difference in 5-year mortality and median graft survival between single and double-lung transplants in patients with chronic obstructive pulmonary disease (COPD).
Evidence Rating Level: 2 (Good)
Study Rundown: Since 2005, lung transplant allocation has been based on medical need, according to a new allocation algorithm called the Lung Allocation Score (LAS). Because of this change as well as changing population demographics in the United States, the patients that are undergoing lung transplants are now older, sicker, and have more comorbidities, such as diabetes mellitus. This study sought to look at the difference in graft survival between single- and double-lung transplant recipients in two different patient populations (i.e., those with COPD and those with IPF) after the initiation of the new allocation algorithm.
The results demonstrated that patients with IPF experience significantly lower mortality from double-lung transplantation as compared with single-lung transplantation. There was no difference in mortality between single- or double-lung transplants for patients with COPD. The study also identified factors that were associated with better and worse outcomes post-transplantation. The strengths of this study included their large cohort base and adjustment for confounding variables. Weakness of the study included the inevitable selection bias for patients receiving lung transplants in the first place. Nevertheless, this study updates mortality statistics for lung transplantation in these populations to reflect the outcomes of the LAS system.
Click to read the study, published today in JAMA
Relevant Reading: Survival after bilateral versus single lung transplantation for patients with chronic obstructive pulmonary disease: a retrospective analysis of registry data
In-Depth [retrospective cohort]: This study is a retrospective cohort study that looked at the survival outcomes of 11,892 patients with COPD and IPF who underwent single- vs. double-lung transplantation since the initiation of the LAS. Patients were categorized into either the COPD or IPF group and data analysis was run on each group independently. Six pre-transplant variables including age, BMI<18 or >35, and complete HLA mismatch were associated with decreased graft survival. Confounding variables were accounted for through propensity score analysis.
After adjusting for potential confounders, the median graft survival in the IPF group was longer after double-lung transplantation vs. single-lung transplantation (65.2 months vs. 50.4 months, respectively, p = 0.001). While unadjusted data demonstrated that double-lung transplant was associated with improved survival in COPD (HR 0.85, 95%CI 0.75-0.96, p = 0.007), the median graft survival between double- and single-lung transplants was not statistically significant following adjustment for known confounders (67.7 months vs. 64.0 months, respectively, p = 0.23). Seven pre-transplant variables including age, pulmonary hypertension, chronic or end-stage kidney disease, and complete HLA mismatch were associated with decreased graft survival.
Image: PD
©2015 2 Minute Medicine, Inc. All rights reserved. No works may be reproduced without expressed written consent from 2 Minute Medicine, Inc. Inquire about licensing here. No article should be construed as medical advice and is not intended as such by the authors or by 2 Minute Medicine, Inc.


![2 Minute Medicine: Pharma Roundup: Price Hikes, Breakthrough Approvals, Legal Showdowns, Biotech Expansion, and Europe’s Pricing Debate [May 12nd, 2025]](https://www.2minutemedicine.com/wp-content/uploads/2025/05/ChatGPT-Image-May-12-2025-at-10_22_23-AM-350x250.png)

![Novel compound may correct pathological airway mucus in cystic fibrosis [PreClinical]](https://www.2minutemedicine.com/wp-content/uploads/2015/03/clubbing-75x75.jpg)
![Paracetamol (Tylenol) ineffective for low-back pain [PACE Study]](https://www.2minutemedicine.com/wp-content/uploads/2014/07/479px-Extra_Strength_Tylenol_and_Tylenol_PM-75x75.jpg)
